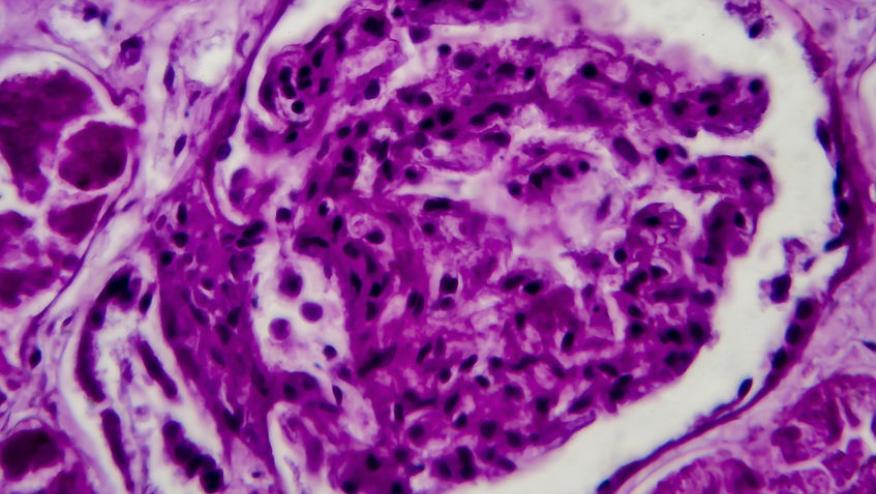

Racial/ethnic disparity in U.S. lupus nephritis mortality Save
At #ACR21, the plenary session included an analysis of deaths from SLE throughout the US comparing 1999 to 2019 (Abstract #0454).
The good news is that mortality from lupus nephritis has reduced compared to earlier years, but with an upstroke between 2015 to 2019. The bad news is that of the 8,899 deaths from lupus nephritis (and overall 25,973 deaths due to SLE), were over-represented by certain racial groups. For instance, black persons represent 12.8% of the population but accounted for 38% of deaths from renal lupus. Conversely, white persons account for nearly 2/3 of the population but represented only 41.5% of lupus nephritis deaths. This resulted in a 6-fold increase in age adjusted standardized mortality rate in black persons with lupus nephritis compared to whites and 2 times higher than other ethnicities. Other ethnicities including Hispanics, American Indians, Alaskans, and Asia Pacific Islanders also had higher mortality from renal lupus compared to white persons. Surprising to me (as resources should be available in large hospitals), the highest mortality for lupus nephritis occurred in large metropolitan areas.
So why is race/ethnicity so linked to mortality in lupus nephritis? Is it due to differences in genes, environmental factors, poverty, socioeconomic status, discrimination in health resources, or all of the above?
I tend to think of genes of getting lupus nephritis and different genes for developing renal damage. In Canada, where there is (sort of) universal health care (for hospitalization, physician visits, but not necessarily for pharmacare), Asians had more renal lupus than black persons and Native peoples but they had less renal damage.1 In Canada the disparities in health outcomes have been seen more in rural areas where access to state-of-the-art treatment and access to subspecialty care may be more difficult.2
These findings need an explanation. A deep look at unconscious biases of health care workers and health system failures is also warranted, as very few polygenic changes will account for 6 times higher discrepancies in mortality.
1. Peschken CA, et al. The 1000 Canadian Faces of Lupus: Determinants of Disease Outcome in a Large Multiethnic Cohort. J Rheumatol 2009; 36(6): 1200-1208.
2. Widdifield J, et al. Quality care in seniors with new-onset rheumatoid arthritis: A Canadian perspective. Arthritis Care Res (Hoboken) 2011 Jan;63(1):53-7. doi: 10.1002/acr.20304.










If you are a health practitioner, you may Login/Register to comment.
Due to the nature of these comment forums, only health practitioners are allowed to comment at this time.